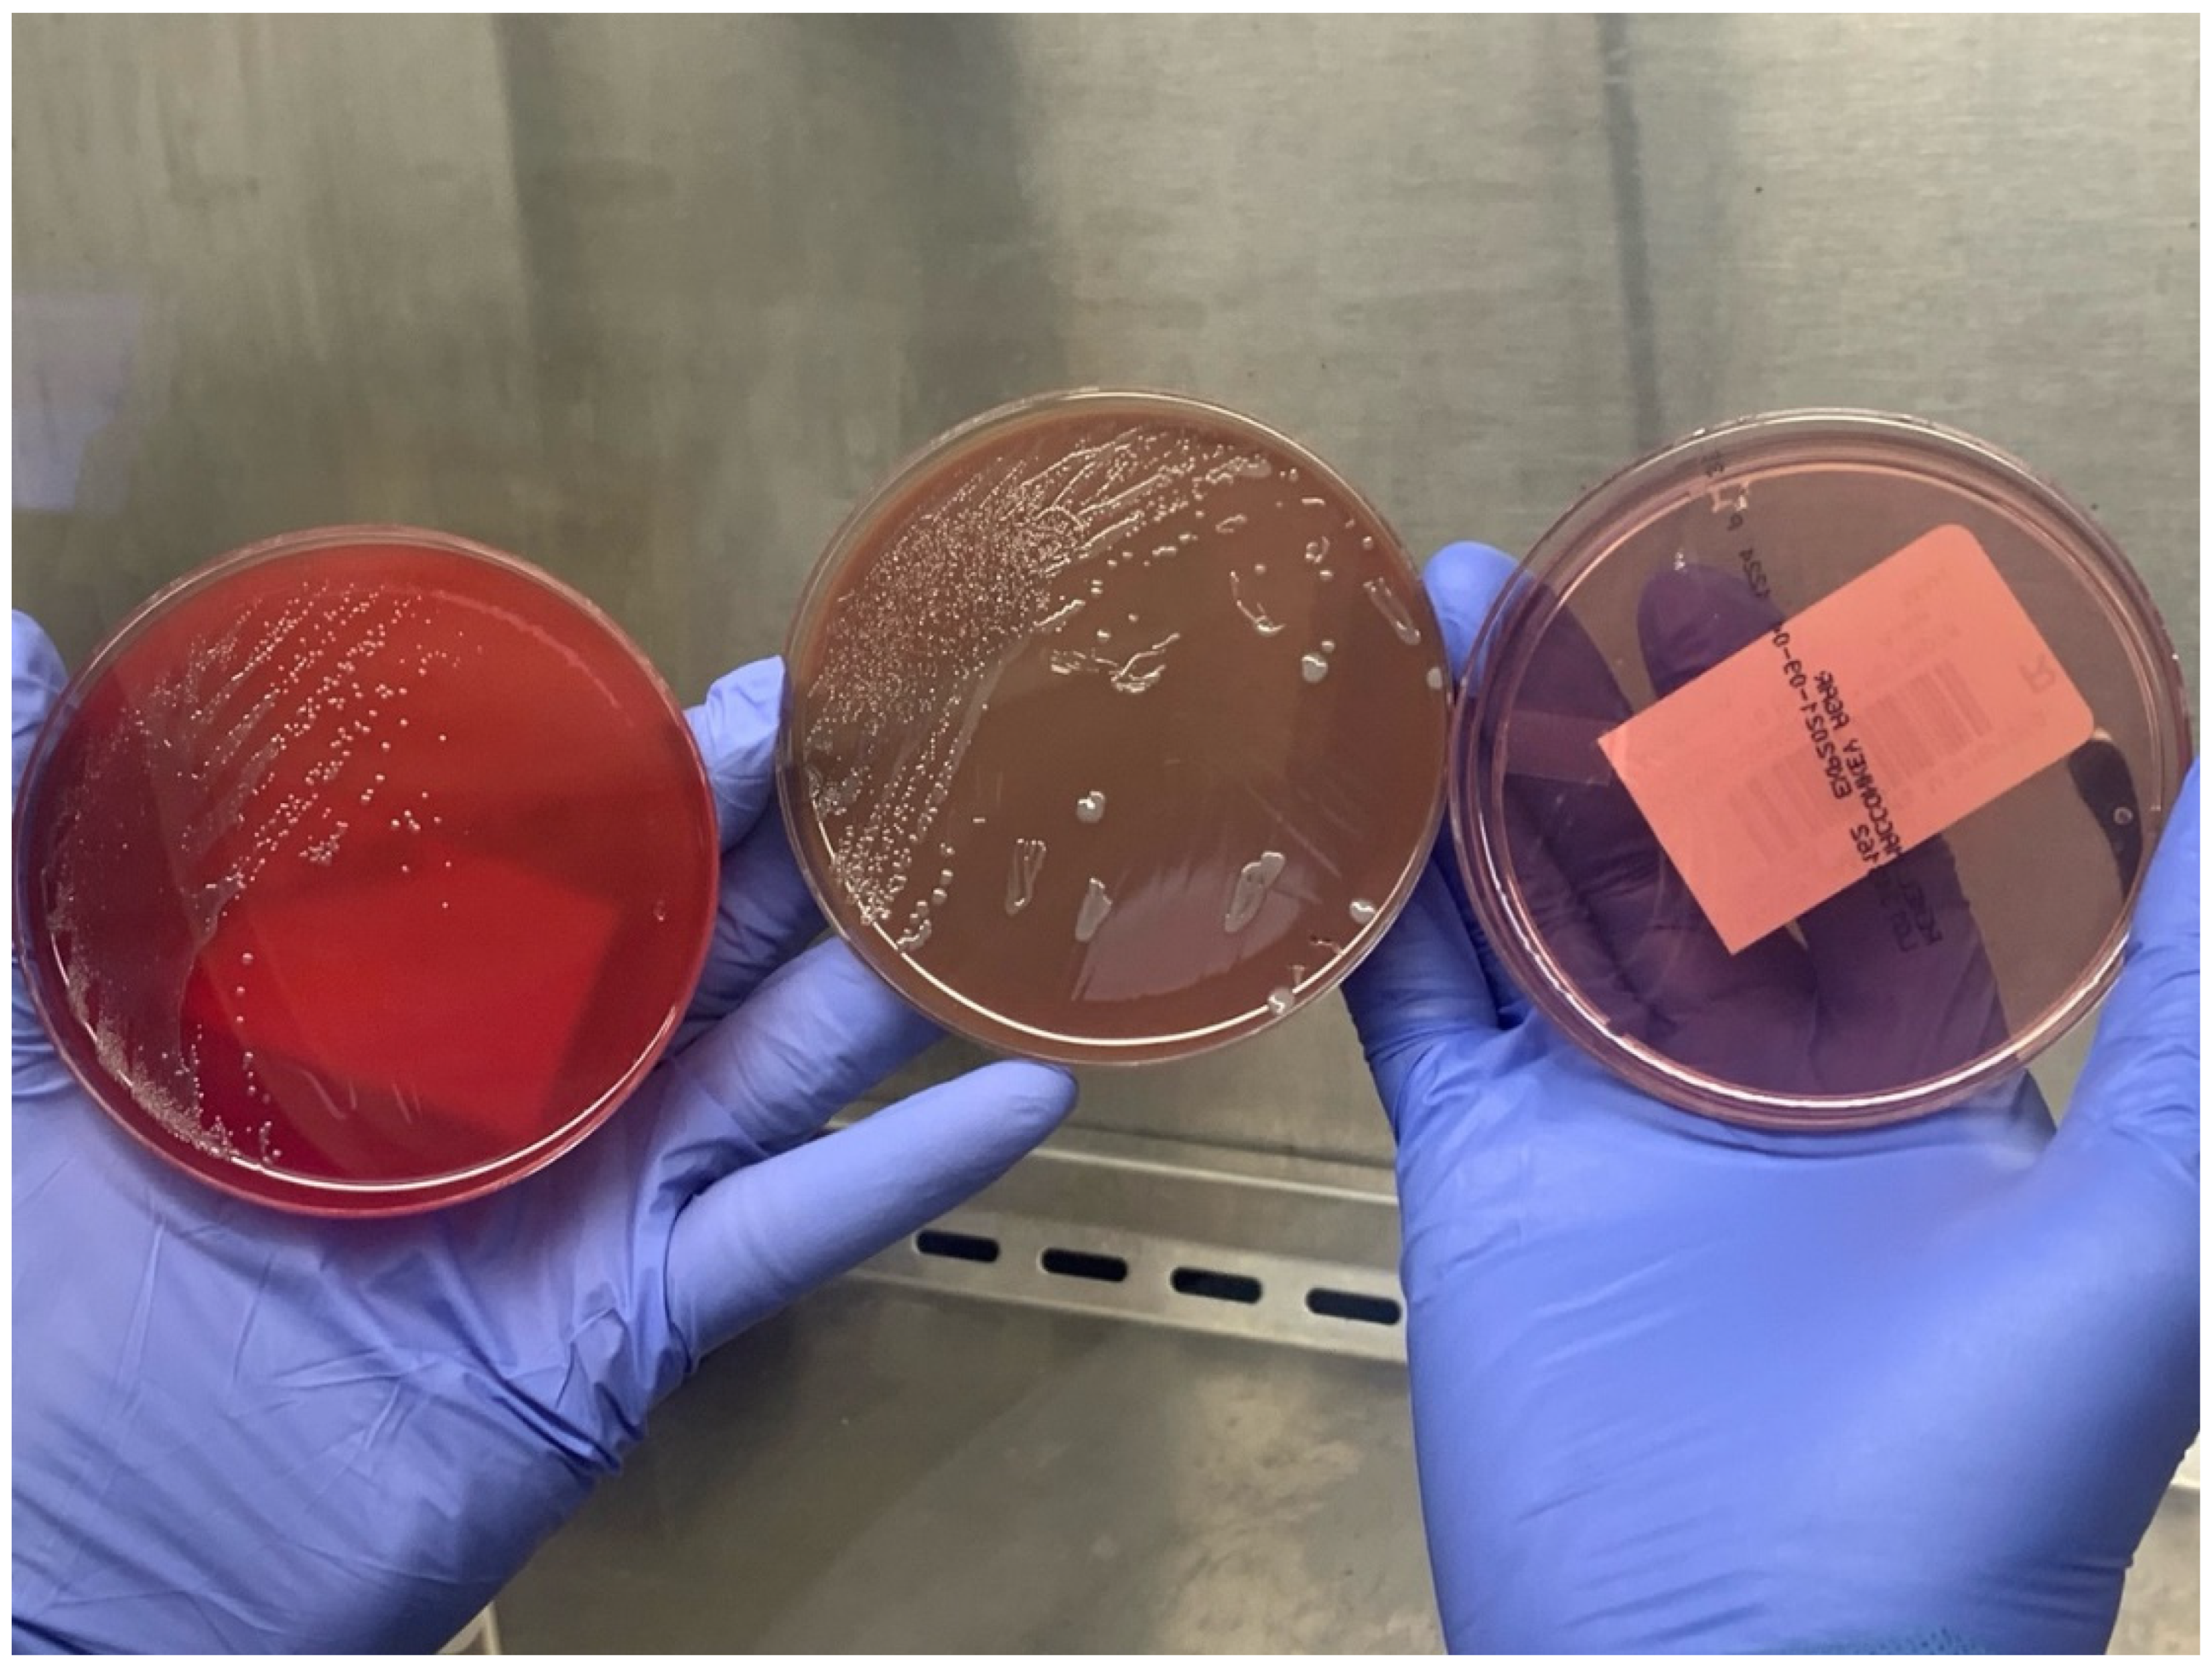
Tropicalmed 07 00220 g002

Fever and Ulcerative Skin Lesions in a Patient Referred for Altered Mental Status: Clinical and Microbiological Diagnosis of Ulceroglandular Tularemia
Abstract
:- “The rabbit’s dreamy eyes grow dreamier
- As he quietly gives you tularemia.”
- A Bulletin Has Just Come In
- -Ogden Nash, 1946
1. Introduction
2. Detailed Case Description
3. Discussion
4. Conclusions
Author Contributions
Funding
Institutional Review Board Statement
Informed Consent Statement
Data Availability Statement
Acknowledgments
Conflicts of Interest
References
- Valente, S.L.; Wemple, D.; Ramos, S.; Cashman, S.B.; Savageau, J.A. Preventive behaviors and knowledge of tick-borne illnesses: Results of a survey from an endemic area. J. Public Health Manag. Pract. 2015, 21, E16–E23. [Google Scholar] [CrossRef] [PubMed]
- Goethert, H.K.; Shani, I.; Telford, S.R., III. Genotypic diversity of Francisella tularensis infecting Dermacentor variabilis ticks on Martha′s Vineyard, Massachusetts. J. Clin. Microbiol. 2004, 42, 4968–4973. [Google Scholar] [CrossRef] [PubMed]
- Feldman, K.A.; Enscore, R.E.; Lathrop, S.L.; Matyas, B.T.; McGuill, M.; Schriefer, M.E.; Stiles-Enos, D.; Dennis, D.T.; Petersen, L.R.; Hayes, E.B. An Outbreak of Primary Pneumonic Tularemia on Martha’s Vineyard. N. Engl. J. Med. 2001, 345, 1601–1606. [Google Scholar] [CrossRef] [PubMed]
- Centers for Disease Control and Prevention (CDC) For Clinicians | Tularemia | CDC. Available online: https://www.cdc.gov/tularemia/clinicians/index.html (accessed on 1 December 2021).
- Frean, J.; Leggat, P.A.; Rotureau, B.; Mas-Coma, S.; Troha, K.; Božani′c, N.; Urbančič, B.; Korva, M.; Avšič-Županc, T.; Battelino, S.; et al. Vector-Borne Tularemia: A Re-Emerging Cause of Cervical Lymphadenopathy. Trop. Med. Infect. Dis. 2022, 7, 189. [Google Scholar] [CrossRef]
- Massachusets Department of Public Health Tick-borne Diseases | Mass.gov. Available online: https://www.mass.gov/tick-borne-diseases (accessed on 17 August 2022).
- Walter, K.S.; Pepin, K.M.; Webb, C.T.; Gaff, H.D.; Krause, P.J.; Pitzer, V.E.; Diuk-Wasser, M.A. Invasion of two tick-borne diseases across New England: Harnessing human surveillance data to capture underlying ecological invasion processes. Proc. R. Soc. B Biol. Sci. 2016, 283, 20160834. [Google Scholar] [CrossRef] [PubMed]
- Kakoullis, L.; Yalcin, A.; AbdelRazek, M.A.; Sasson, J.P.; Behlau, I. Powassan virus infection presenting as acute encephalitis in a patient from the New England area: A case report. Neurol. Sci. 2022, 43, 5119–5123. [Google Scholar] [CrossRef] [PubMed]
- Nelson, C.; Kugeler, K.; Petersen, J.; Mead, P. Centers for Disease Control and Prevention (CDC) Tularemia—United States, 2001–2010. MMWR. Morb. Mortal. Wkly. Rep. 2013, 62, 963–966. [Google Scholar]
- Farlow, J.; Wagner, D.M.; Dukerich, M.; Stanley, M.; Chu, M.; Kubota, K.; Petersen, J.; Keim, P. Francisella tularensis in the United States. Emerg. Infect. Dis. 2005, 11, 1835. [Google Scholar] [CrossRef] [PubMed]
- Maurin, M. Francisella tularensis as a potential agent of bioterrorism? Expert Rev. Anti-Infect. Ther. 2015, 13, 141–144. [Google Scholar] [CrossRef] [PubMed]
- McLendon, M.K.; Apicella, M.A.; Allen, L.A.H. Francisella tularensis: Taxonomy, Genetics, and Immunopathogenesis of a Potential Agent of Biowarfare. Annu. Rev. Microbiol. 2006, 60, 167. [Google Scholar] [CrossRef] [PubMed]
- DPDx Laboratory Identification of Parasites of Public Health Concern; CDC Ticks. Available online: https://www.cdc.gov/dpdx/ticks/index.html (accessed on 8 January 2022).
- Faget, J.-C. Et exposé succinct d’une endémie paludéenne, de forme catarrhale, qui a sévi à la Nouvelle-Orléans, particulièrement sur les enfants, pendant l’épidémie de fièvre jaune de 185. In Étude Médicale de Quelques Questions Importantes Pour la Louisiane; Imprimerie Franco-Américaine: New Orleans, LA, USA, 1859. [Google Scholar]
- Ye, F.; Hatahet, M.; Youniss, M.A.; Toklu, H.Z.; Mazza, J.J.; Yale, S. The clinical significance of relative bradycardia. Wis. Med. J. 2018, 117, 73–78. [Google Scholar]
- Eliasson, H.; Sjöstedt, A.; Bäck, E. Clinical use of a diagnostic PCR for Francisella tularensis in patients with suspected ulceroglandular tularaemia. Scand. J. Infect. Dis. 2009, 37, 833–837. [Google Scholar] [CrossRef] [PubMed]
- Penn, R. Francisella tularensis (Tularemia). In Mandell, Douglas, and Bennett’s Principles and Practice of Infectious Diseases; Bennett, J.E., Dolin, R., Blaser, M.J., Eds.; Elsevier Health Sciences: Amsterdam, The Netherlands, 2014; pp. 2590–2602. [Google Scholar]

| Laboratory Parameter | Value |
|---|---|
| WBC | 9430 cells/mL |
| Hb | 14.1 g/dL |
| PLT | 74,000 cells/mL |
| Na | 130 mmol/L |
| K | 3.8 mmol/L |
| HCO3 | 19 mmol/L |
| BUN | 42 mg/dL |
| Cr | 1.4 mg/dL |
| ALT | 26 U/L |
| AST | 75 U/L |
| Total bilirubin | 0.9 mg/dL |
| INR | 3.2 |
| LDH | 1384 U/L |
| CPK | 507 U/L |
| CRP | 449.5 mg/L |
| ESR | 76 mm/h |
Publisher’s Note: MDPI stays neutral with regard to jurisdictional claims in published maps and institutional affiliations. |
© 2022 by the authors. Licensee MDPI, Basel, Switzerland. This article is an open access article distributed under the terms and conditions of the Creative Commons Attribution (CC BY) license (https://creativecommons.org/licenses/by/4.0/).
Share and Cite
Kakoullis, L.; Pitman, J.; Flier, L.; Colgrove, R. Fever and Ulcerative Skin Lesions in a Patient Referred for Altered Mental Status: Clinical and Microbiological Diagnosis of Ulceroglandular Tularemia. Trop. Med. Infect. Dis. 2022, 7, 220. https://doi.org/10.3390/tropicalmed7090220
Kakoullis L, Pitman J, Flier L, Colgrove R. Fever and Ulcerative Skin Lesions in a Patient Referred for Altered Mental Status: Clinical and Microbiological Diagnosis of Ulceroglandular Tularemia. Tropical Medicine and Infectious Disease. 2022; 7(9):220. https://doi.org/10.3390/tropicalmed7090220
Chicago/Turabian StyleKakoullis, Loukas, Justin Pitman, Lydia Flier, and Robert Colgrove. 2022. "Fever and Ulcerative Skin Lesions in a Patient Referred for Altered Mental Status: Clinical and Microbiological Diagnosis of Ulceroglandular Tularemia" Tropical Medicine and Infectious Disease 7, no. 9: 220. https://doi.org/10.3390/tropicalmed7090220
APA StyleKakoullis, L., Pitman, J., Flier, L., & Colgrove, R. (2022). Fever and Ulcerative Skin Lesions in a Patient Referred for Altered Mental Status: Clinical and Microbiological Diagnosis of Ulceroglandular Tularemia. Tropical Medicine and Infectious Disease, 7(9), 220. https://doi.org/10.3390/tropicalmed7090220

